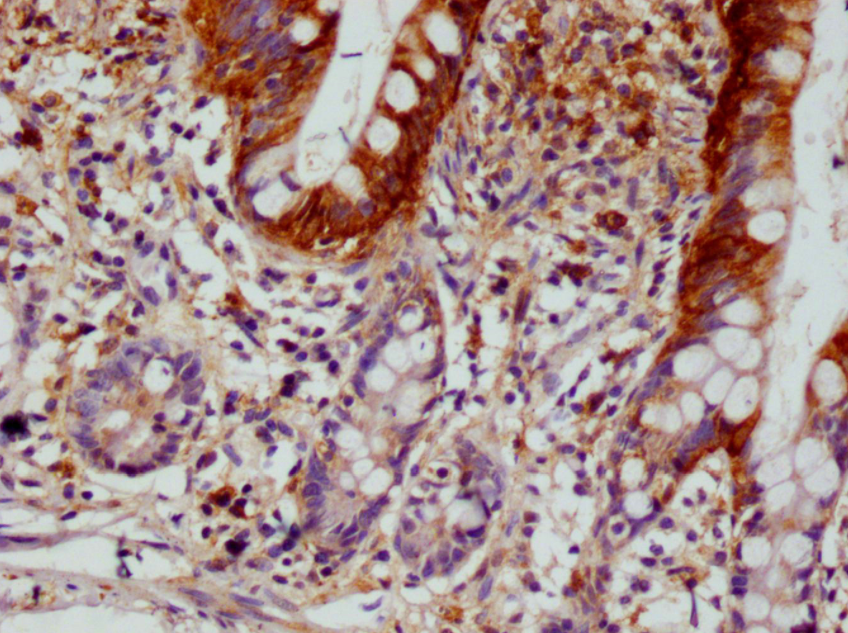
A74580.png

PRODUCT CENTER
特色產(chǎn)品當(dāng)前位置:首頁 > 特色產(chǎn)品
一種依賴Ca2+的肌動蛋白絲斷裂蛋白,通過影響質(zhì)膜下微絲網(wǎng)絡(luò)的組織結(jié)構(gòu),在外泌作用中發(fā)揮調(diào)節(jié)功能。其斷裂活性可被磷脂酰肌醇4,5-二磷酸(PIP?)抑制(根據(jù)相似性推斷)。在體外,該蛋白在Ca2+存在時還具有肌動蛋白絲末端封蓋和成核活性。該蛋白對于巨核細胞的分化、成熟、多倍體化以及凋亡(伴隨血小板樣顆粒的釋放)是必需的。它在破骨細胞生成(OCG)和破骨細胞中肌動蛋白細胞骨架的組織結(jié)構(gòu)中發(fā)揮作用(根據(jù)相似性推斷)。它還調(diào)節(jié)軟骨細胞的增殖和分化(根據(jù)相似性推斷)。此外,該蛋白能夠抑制細胞增殖和腫瘤發(fā)生。其信號傳導(dǎo)通過MAPK、p38和JNK通路介導(dǎo)。
SCIN重組單克隆抗體 [12B11]。未偶聯(lián)。宿主:HEK293F細胞。
作為Epigentek在中國區(qū)域合作伙伴,艾美捷科技強烈推薦Epigentek熱銷產(chǎn)品SCIN 重組單克隆抗體 [12B11]。產(chǎn)品僅用于科研,不可用于臨床診斷。
| 產(chǎn)品名稱 | 貨號 | 詳情 |
| SCIN 重組單克隆抗體 [12B11] | A74580-100 | 查看 |
SCIN 重組單克隆抗體 [12B11]:
緩沖液:兔IgG,磷酸鹽緩沖液,pH 7.4,150 mM NaCl,0.02%疊氮化鈉和50%甘油。
特異性:人
亞型:兔IgG
純化方法:親和層析
免疫原:來源于人SCIN的合成肽
儲存條件:收到后,儲存于-20℃或-80℃。避免反復(fù)凍融。
別名:Adseverin(Scinderin),SCIN,KIAA1905
應(yīng)用:ELISA、IHC;推薦稀釋度:IHC:1:50-1:200
IHC圖像說明
SCIN重組單克隆抗體稀釋度為1:100,在Leica Bond系統(tǒng)上對石蠟包埋的人小腸組織進行染色。脫蠟和水化后,通過在檸檬酸緩沖液(pH 6.0)中高壓處理進行抗原修復(fù)。切片用10%正常山羊血清在室溫下封閉30分鐘,然后用1% BSA的初級抗體在4℃下孵育過夜。初級抗體通過辣根過氧化物酶標(biāo)記的山羊抗兔聚合IgG檢測,并使用0.05% DAB進行顯色。
Epigentek集團公司是全球領(lǐng)先的創(chuàng)新技術(shù)和表觀遺傳學(xué)相關(guān)研究產(chǎn)品的開發(fā)商和供應(yīng)商。公司開發(fā)了包括400多個專利產(chǎn)品的全面的產(chǎn)品組合,為表觀遺傳學(xué)方面的研究和新藥研發(fā)提供全面系統(tǒng)的解決方案。作為Epigentek 的中國區(qū)域代理,艾美捷科技為中國客戶提供包括DNA甲基化研究工具、染色質(zhì)結(jié)構(gòu)分析、組蛋白甲基化研究、乙酰化與去乙酰化分析、DNA損傷與修補、組蛋白磷酸化、蛋白泛素化等系列研究試劑盒和抗體產(chǎn)品等全系列解決方案。

微信掃碼在線客服